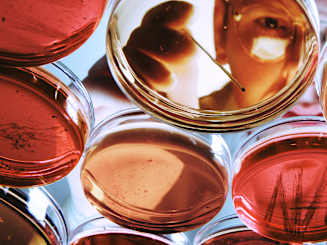
Navigating Risk in Life Sciences: Building Resilience to Support Growth

Collection

The insurance industry is navigating a complex mix of risks that are reshaping its operating environment, complicating underwriting assumptions and exposing the limitations of traditional risk frameworks.
At the same time, rising capital pressure and earnings volatility, driven by higher retention and declining reserve adequacy, are forcing insurers to rethink how they can grow profitably in a soft market. Meeting elevated expectations from clients and capital providers will require embedding strategic relevance into every decision.
According to Aon’s Global Risk Management Survey, insurance industry respondents across risk management, finance and the C-suite identify the following risks as the most critical challenges facing their organizations today.

Collection
Cyber risk continues to dominate the insurance sector’s risk landscape and is growing in complexity. Insurers face dual exposure: protecting their own operations and underwriting cyber risk for clients. This overlap creates unique vulnerabilities that demand integrated resilience.
The industry’s reliance on sensitive data, interconnected systems and third-party platforms makes it a prime target for sophisticated attacks. Ransomware campaigns increasingly target insurers for high-value data, while compromise of business emails and manipulation of claims or policy data by fraudsters are persistent threats. Shared market platforms and aggregators for policy administration, claims, and data exchange can rapidly propagate a breach across multiple organizations, amplifying the impact of a single cyber event.
For example, claims processing systems may be locked or corrupted, delaying payouts and damaging customer trust. Policy administration platforms could be compromised, leading to data loss or unauthorized changes, or customer portals and digital channels may be taken offline, impacting service delivery and sales.
From an underwriting perspective, the maturing cyber insurance market presents new opportunities for profitable growth. Despite a surge in claims frequency, average payment amounts have declined, reflecting improved underwriting discipline and a focus on robust cyber security controls. With ample capacity and competitive pricing, insurers have expanded coverage and limits while growing their cyber portfolios. At the same time, they are investing in advanced modeling and incident response capabilities to manage systemic risk and sustain profitability.
As insurers capitalize on these opportunities, maintaining a balanced approach is essential. Cyber resilience must be embedded across both operations and underwriting to protect insurers’ organizations and to strengthen the risk profiles of insureds. This includes enforcing access controls, encrypting data, testing response plans and managing third-party risk. As the cyber risk landscape rapidly evolves with the adoption of AI, disciplined underwriting, advanced modeling and strong oversight will be key to managing systemic risk and sustaining profitability.
Climate change and natural disasters are ranked separately in our survey, but their effects are deeply intertwined. Climate change not only drives regulatory shifts and transition risks but also can influence the behavior of natural disasters, which cause direct property damage. Together, they represent a systemic challenge to underwriting, pricing and capital allocation.
As a result of higher exposure and climate shifts, weather-related disasters are not only more frequent than they used to be — they are also more destructive. In 2024 alone, global natural disasters resulted in $368 billion in economic losses, with only 40 percent insured. These perils are eroding insurer earnings and creating volatility in underwriting performance. In highly exposed markets, profitability is becoming more fragile, especially where treaty structures and pricing models have not adapted to the new risk landscape.
The impact of climate-related events is often magnified by concentration risk — ranked tenth in our survey — where large volumes of insured assets are clustered in high-exposure regions. Natural disasters such as hurricanes, floods and wildfires can trigger outsize losses when they strike densely populated or economically critical areas, particularly where insurers have significant portfolio exposure. This geographic and asset concentration amplifies the financial and operational consequences of extreme weather, making diversification and scenario modeling essential components of climate risk management.
For insureds, this means coverage availability and affordability are under pressure, making relevance a strategic imperative for insurers seeking to maintain trust and deliver value. To manage the systemic threat of climate change, insurers must evolve their approach to risk modeling, capital deployment and product innovation. Forward-looking climate diagnostics and portfolio-specific analytics are essential to understand exposure and inform underwriting.
Geopolitical volatility surged in 2025, driven by trade tensions and regional conflicts. For insurers, this has introduced uncertainty across claims, demand and investment strategies.
This affects insurers’ portfolios, but it also poses direct risk management challenges for insurance organizations. Heightened political tensions, sanctions and regulatory shifts can disrupt global operations and access to key markets. Insurers must proactively monitor geopolitical developments, stress test their own exposures, and ensure crisis management and business continuity plans are robust and regularly updated.
Elevating geopolitical risk oversight to the board level helps organizations anticipate emerging threats and respond with agility, turning risk management into a source of resilience and competitive advantage.

Global Risk Management Survey
Looking ahead, Aon’s Global Risk Management Survey shows insurers expect cyber risk to remain dominant as AI adoption accelerates. Climate change and escalating weather events also remain critical, with long-term implications for underwriting and resilience.
AI is driving competition and reshaping the insurance sector — enabling automation, more personalized client engagement and smarter underwriting. AI is being used to automate submission intake, eligibility checks and risk profiling, enabling faster, more accurate decisions. Agentic AI is supporting end-to-end policy processing, while generative AI is refining some underwriting guidelines in real time. These capabilities can reduce adverse selection and enable hyper-personalized products.
From a risk management perspective, however, rapid AI adoption is introducing new challenges related to governance, ethics and workforce disruption. Poor implementation can lead to inaccurate pricing, disengaged employees and reputational damage. The talent needed to manage AI — including data scientists, ethicists and tech-savvy leaders — is in short supply.
Shifting to the underwriting perspective, AI is an emerging exposure for insurers to assess and cover. As adoption accelerates, some insurers are beginning to underwrite AI-related risks across multiple lines, including cyber, errors and omissions, and directors and officers. However, coverage is often fragmented, with some policies offering silent or ambiguous protection.
In response, insurers are introducing AI-specific endorsements and affirmative language to address exposures such as model failure, data poisoning and algorithmic bias, and they are increasingly requiring insureds to demonstrate strong governance, transparency and clear disclosure as prerequisites for insurability.
To succeed, insurers must take a holistic approach to AI — strengthening both operational resilience and underwriting discipline. Establishing robust governance frameworks to manage bias, privacy and compliance is critical, as is upskilling and cross-functional collaboration to ensure AI strengthens (rather than weakens) the organization. At the same time, insurers must continue to refine their underwriting strategies, ensuring AI-related exposures are clearly understood, appropriately priced and transparently communicated to clients.
Failure to attract or retain top talent appears in the list of current top risks but falls out of the top ten future risks. This is surprising, given that a significant portion of the insurance workforce is approaching retirement — potentially up to 50 percent by the mid-2030s — and the industry faces a looming talent gap, notably within claims.
At the same time, younger generations remain hesitant to pursue careers in insurance, often perceiving it as outdated or lacking purpose. This perception challenge, combined with shifting workplace expectations, suggests talent attraction and retention should be higher on the agenda for insurers.
This challenge is compounded by the need for new capabilities — digital literacy (including AI), data analytics and cross-disciplinary thinking. Traditional recruitment and retention strategies are no longer sufficient.
To mitigate talent risk, insurers should take a more strategic and proactive approach. This includes developing targeted outreach programs to engage students and early-career professionals, offering flexible career pathways and hybrid work models, and investing in leadership development for emerging talent.
Embedding purpose-driven messaging, sustainability goals and innovation into employer branding can help reposition insurance as a future-focused industry. Internally, insurers should use data-driven workforce planning, AI-enabled skills assessments and mentorship networks to build resilient, future-ready teams.
Against this backdrop of rising risk complexity, from cyber and climate to AI and geopolitical volatility, some insurers are outperforming by taking a more strategic, forward-looking approach. The following traits distinguish those organizations that are not just adapting but leading. They typically do the following:
1. Redefine growth strategy: Refine risk appetite, leverage analytics and prioritize innovation in underwriting to capture emerging risks and new markets.
2. Align capital with strategy: Streamline capital structures and allocation to support strategy, enhance flexibility and maximize efficiency with partners.
3. Invest in data-driven decision-making: Embed analytics and AI into decision-making, strengthen data foundations and upskill teams for continuous improvement and innovation.
4. Understand client and channel needs: Deepen client and broker segmentation, prioritize key channels and use real-time insights.
5. Rethink talent strategy for the next cycle: Align talent with business needs, use data-driven workforce planning and smart assessments, and recruit more broadly to build diverse, future-ready teams.
6. Elevate risk management to a strategic, board-level priority: High-performing insurers recognize that effective risk management is not just a compliance function; it’s also a core value driver. Embed risk oversight into board agendas and decision-making to anticipate emerging threats, respond with agility, and unlock opportunities for sustainable growth.

Global Risk Management Survey
We are in an era of significant change, where risks are converging, accelerating and becoming harder to manage. But within this complexity lies opportunity. Insurers that embrace innovation, invest in talent and adopt a strategic mindset will be able to lead through this period of disruption and continue to protect people and organizations alike.
General Disclaimer
This document is not intended to address any specific situation or to provide legal, regulatory, financial, or other advice. While care has been taken in the production of this document, Aon does not warrant, represent or guarantee the accuracy, adequacy, completeness or fitness for any purpose of the document or any part of it and can accept no liability for any loss incurred in any way by any person who may rely on it. Any recipient shall be responsible for the use to which it puts this document. This document has been compiled using information available to us up to its date of publication and is subject to any qualifications made in the document.
Terms of Use
The contents herein may not be reproduced, reused, reprinted or redistributed without the expressed written consent of Aon, unless otherwise authorized by Aon. To use information contained herein, please write to our team.
Global Risk Management Survey